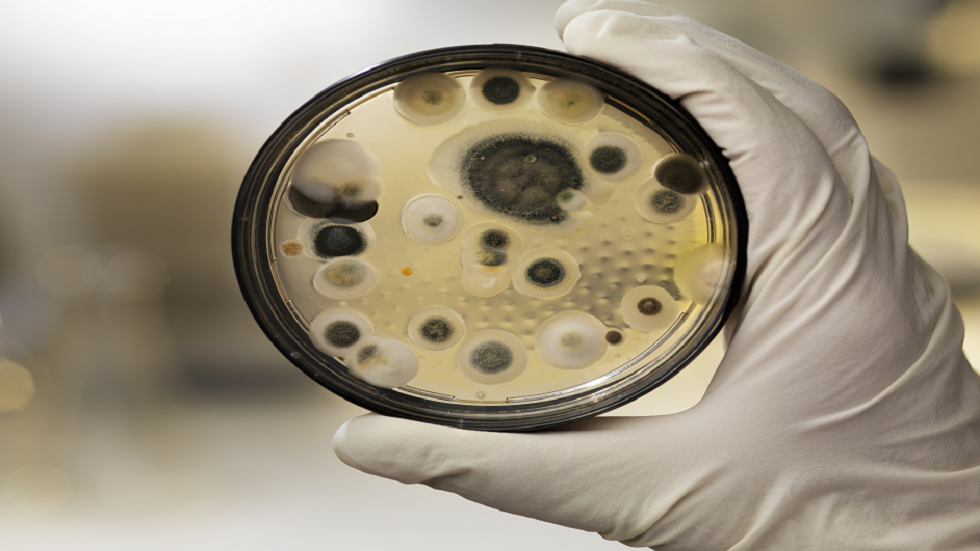
العثور على فطريات قاتلة جديدة في نصف الولايات الأمريكية!

نوع جديد من الفطريات يهاجم الدماغ البشري!
أفادت صحيفة "Daily Mail" أن الأطباء قلقون من انتشار نوع جديد من فطر داء البقع البيضاء (فطر الكانديدا أوريس- Candida auris) الذي أصبح أكثر مقاومة للأدوية.


أزمة عالمية قد تؤدي إلى تفشي الفطريات القاتلة!
وتشير الصحيفة إلى أن أحدث ضحايا هذا الفطر كان رجلا يبلغ من العمر 34 عاما من سكان رأس الخيمة في الإمارات العربية المتحدة.
ووفقا للصحيفة، تعرّض الرجل لحادث أسفر عن إصابته بجروح خطيرة في الرأس، وخضع لعملية جراحية، لكنه لم يتعافَ. وبعد إجراء فحوصات دقيقة، اكتشف الأطباء أن دماغه مصاب بفطريات داء البقع البيضاء، ويرجح أن الفطر دخل إلى الدماغ عبر الجروح التي لحقت به إثر الحادث.
وقال الأطباء المشرفون على علاج الرجل: "إن الإفراط في استخدام الأدوية المضادة للفطريات في الزراعة والرعاية الصحية ساهم في تطوير مقاومة لفطر الكانديدا أوريس ضد تلك الأدوية."
ووفقا لمنظمة الصحة العالمية، يعد فطر داء البقع البيضاء واحدا من أشد 19 نوعا من الفطريات فتكا في العالم، حيث يتسبب بالوفاة في حالة واحدة من كل ثلاث إصابات. ويمكن لهذا الفطر البقاء حيّا على أسطح المستشفيات والجلد لفترات طويلة، وغالبا ما يكون مقاوما للمطهّرات والأدوية، كما يمكنه الانتقال إلى النخاع الشوكي والعظام وتجويف البطن والأذنين والرئتين والمسالك البولية.
وتشير الصحيفة إلى أن الرجل نجا بفضل تلقيه عشرات الحقن والقطرات المضادة للفطريات، بالإضافة إلى دورة علاجية استمرت 11 يوما تناول خلالها أدوية مضادة للفطريات.
المصدر: aif.ru
إقرأ المزيد

"الفطر الفائق" يهدد أوروبا.. مقاومة للأدوية وانتشار سريع!
ينتشر في أوروبا بسرعة كبيرة فطر شديد العدوانية ومقاوم للأدوية، أطلق عليه العلماء اسم "الفطر الفائق".

روسيا.. ابتكار مرهم من الفطر لعلاج الحروق الشديدة
أثبت خبراء جامعة الأورال الفيدرالية أن المراهم التي تحتوي على مستخلص فطر الصوفان تسرع تعافي الجلد بعد الحروق الشديدة من خلال تحفيز تجديد الأنسجة وكبح العمليات الالتهابية.

طريقة بسيطة لتحسين التركيز وتنشيط الدماغ
كشفت دراسة علمية حديثة عن طريقة بسيطة تساعدنا على تحسين التركيز واستعادة نشاط الدماغ.

الدنمارك.. اكتشاف نوع جديد من الفطريات تحوّل العناكب إلى زومبي
قام فريق من العلماء، بمن فيهم متخصصون من متحف التاريخ الطبيعي في الدنمارك والحدائق النباتية الملكية في كيو، بإجراء بحث لتحديد نوع الفطريات التي ظهرت على العناكب.

"حرائق الغابات وتغير المناخ: الفطريات القاتلة تهدد البشرية بجائحة مستقبلية"
يحذر الخبراء من أن فكرة انتشار وباء "زومبي" بسبب فطر قاتل، والتي كانت تُعتبر خيالاً علمياً، قد تصبح أقرب إلى الواقع مما نتصور، خاصة مع تزايد حرائق الغابات.
العثور على فطريات قاتلة جديدة في نصف الولايات الأمريكية!
تنتشر بكتيريا فطرية خارقة تسمى Candida auris بسرعة عبر المستشفيات ودور رعاية المسنين في الولايات المتحدة.

طبيب روسي يكشف المكان الأخطر لانتقال عدوى الفطريات
أعلن الدكتور ألكسندر مياسنيكوف، أن مسار الإصابة بـ "كوفيد-19" لدى بعض المرضى يتعقد بسبب الإصابة الثانوية.

دراسة: الفطريات تتحاور مع بعضها مستخدمة مفردات تصل إلى 50 كلمة!
وجدت دراسة حديثة أن الفطر يمكنه "التحدث" مع بعضه البعض ويملك مفردات تصل إلى 50 كلمة.























































































































التعليقات